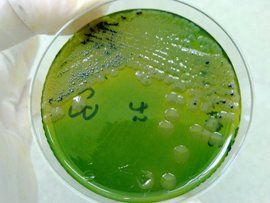
弧菌 弧菌

形態
弧菌弧菌菌體只有一個彎曲,呈弧狀或逗點狀。如霍亂弧菌。革蘭氏染色陰性,長0.8~3μm、寬0.5~1.5μm,從病人新分離的細菌形態典型,人工培養後常呈桿狀而不易與其他腸道菌區別。取病人米泔水樣糞便直接塗片染色鏡檢,可見其相互排列如“魚群”狀。無芽孢和莢膜,有菌毛和一根單鞭毛,運動非常活潑。懸滴觀察,可見其呈穿梭或流星樣運動。
弧菌弧菌基因組由2條環狀染色體
組成。大染色體約2.91 Mb,G+C 占46.9%;小染色體約1.072 Mb,G+C 占47.7%。總共有3 885個開放閱讀框(ORF)。霍亂毒素基因位於大染色體上整合的溫和絲狀噬菌體CTXΦ基因組內。
感染病症
該菌引起的食物中毒經烹飪不當的海產品或鹽醃製品所傳播。常見的為海蟄、海魚、海蝦及各種貝類,因食物容器或砧板生熟不分污染本菌後,也可發生食物中毒。該菌常年均可發生,潛伏期5~72小時,平均24小時,可從自限性腹瀉至中度霍亂樣病症,有腹痛、腹瀉、嘔吐和低熱,糞便多為水樣,少數為血水樣,恢復較快,病後免疫力不強,可重複感染。
該菌還可引起淺表創傷感染、敗血症等。
危害分類
弧菌副溶血弧菌腸炎是由
致病性副溶血弧菌引起的急性胃腸炎。
河弧菌腸炎
河弧菌腸炎由河弧菌(V.fluvialis)引起。河弧菌可引起散發性腹瀉,在英國、美國、西班牙、非洲、中東、東南亞均有發病,各年齡組易感,但以嬰幼兒和青少年多見。臨床上有噁心、嘔吐、腹痛及腹瀉。腹瀉量較多,有每天達7L者,因此常伴失水。少數糞便帶粘液或血。病程1~3天。糞便排菌量甚高,可達10 /ml,置含氯化鈉3%~7%條件下生長良好。
擬態弧菌(V.mimicus)與不典型的霍亂弧菌關係密切,性質相似,故於1981年命名為“擬態弧菌”。菌株在不含鈉或僅含1%氯化鈉的營養肉湯中生長良好,在河水和海水中均可生存,可自水生動物中分離出來。在美國、北美、紐西蘭、孟加拉及非洲國家均有病例報導。中國福建、北京、上海、江蘇及浙江地區也有發病。呈散發或爆發。潛伏期3~72h,平均24h。主要症狀有腹瀉、嘔吐及腹痛,大便呈水樣或粘液血便。
弧菌霍利斯弧菌(V.hollisae)為嗜鹽性弧菌,在培養基上有微弱的溶血環。本菌存在於海水中,患者病前大多有進食海產品史。發病以青壯年為多。腹瀉症狀嚴重,呈水樣便,粘液便,少數呈血便。輕者自愈,重者應補液糾正失水及電解質紊亂。
溶藻性弧菌為海水中常見嗜鹽性弧菌,1973年開始明確對人類致病,易污染食物,引起腹瀉及創傷部位感染。
創傷弧菌感染
創傷弧菌(V.vulnificus)於1964年美國CDC自腹瀉患者糞便分離出來。該菌可自海水、貝殼類及海魚中分離到。發病以夏季為多。常在進食後24h發病。患者大多有發熱、畏寒、嘔吐及腹瀉。除經口感染外,可經皮膚傷口入侵而發生局部感染並引起敗血症,嚴重者發生DIC、休克並致死。有認為本菌系條件致病菌,在慢性病伴免疫功能低下者、高齡、糖尿症、血液病患者易發生嚴重敗血症。
弗尼斯弧菌感染
此病首先發現於日本及東方一些國家,其後擴散至西方國家。呈爆發流行或散發性急性胃腸炎。臨床上以腹瀉及腹痛為主,伴噁心及嘔吐。也有嚴重致死病例報導。此菌存在於海洋,產生腸毒素,為旅遊者腹瀉的病原之一。
診斷與防治
弧菌性腸炎發病以沿海地區為多,或患者有去沿海地區旅遊及進海產品史。病原診斷應取糞便接種於特異性培養基,如TCBS。有弧菌生長再進行生化鑑定。
標本採取患者糞便、肛拭或剩餘食物,直接分離培養於SS瓊脂平板或嗜鹽菌選擇平板。如出現可疑菌落,進一步作嗜鹽性試驗與生化反應,最後用診斷血清進行鑑定。最近已發展了基因探針雜交及PCR快速診斷法,可直接從原始食物標本或腹瀉標本中檢測耐熱毒素基因。
治療可用抗菌藥物,如慶大黴素或複方SMZ-TMP,嚴重病例需輸液和補充電解質。
相關研究
2012年7月23日,英國環境、漁業以及水產養殖科學中心研究警告稱,因全球變暖,大量病菌正在入侵北歐,導致霍亂和腸胃炎等疾病增加。
這項研究主要集中於波羅的海,因為這裡正以空前的速度變暖,100年間海水溫度上升了6.3到7.8攝氏度。研究人員發現,波羅的海溫度上升促使水生細菌弧菌增長加速。弧菌通過食用貝類或海水進入人體後會引發多種感染疾病,包括霍亂、腸胃炎等。研究發現,水溫每上升一攝氏度,弧菌數量就會增加200%。科學家警告稱,隨著海洋溫度持續上升,歐洲北部地區沿海海水鹽度在下降,弧菌正不斷擴散。